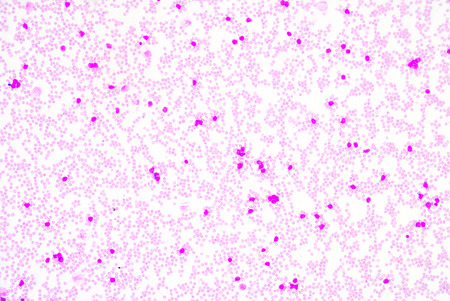
White blood cells of a human, photomicrograph panorama as seen under the microscopeの写真素材

写真素材 - White blood cells of a human, photomicrograph panorama as seen under the microscope
作品情報
White blood cells of a human, photomicrograph panorama as seen under the microscope
- ID:38281722
- 作品種別:写真
- 作者名:toeytoey
キーワード
- basophil
- biology
- blood
- body
- cell
- diagram
- disease
- elements
- eosinophil
- granules
- granulocyte
- health
- healthy
- heart
- hemoglobin
- human
- immune
- infection
- leukemia
- leukocyte
- lymphocyte
- macro
- marrow
- medical
- medicine
- microbiology
- mono
- monocyte
- neutrophil
- nuclear
- nucleus
- organ
- overview
- platelets
- red
- schematic
- science
- scientific
- smear
- stem
- structure
- system
- vascular
- white
- anatomy
類似作品
Polycythemia ve...
Red and white b...
A 3D rendering ...
Red blood cells...
Red bubbles of ...
3d red blood ce...
Red bubbles of ...
3d illustration...
Red blood cells...
Abstract backgr...
Human red blood...
Image of micro ...
Red blood cell ...
Creative ebru a...
lava red lamp f...
Red blood cell ...
Red blood cells...
Blood vessel wi...
red blood cell ...
Healthy human r...
blood smear is ...
microscope lens...
Red blood cells...
3d rendering wh...
3d rendered med...
Very high resol...
Clouds of small...
Immunity. Red b...
Red and white b...
Microcosmos vol...
3D rendering il...
Intense clutter...
white lymphocyt...
Realistic molec...
Plastic eyes fo...
Medical anatomi...
3d rendered ill...
Blood of sickle...
Close-up of ery...
Magnified pictu...
Aggressive viru...
Nanoparticles i...
3d rendered med...
blood smear is ...
Red blood cells...
White blood cel...
Red blood cells...
Chromosome on s...
Graphic image o...